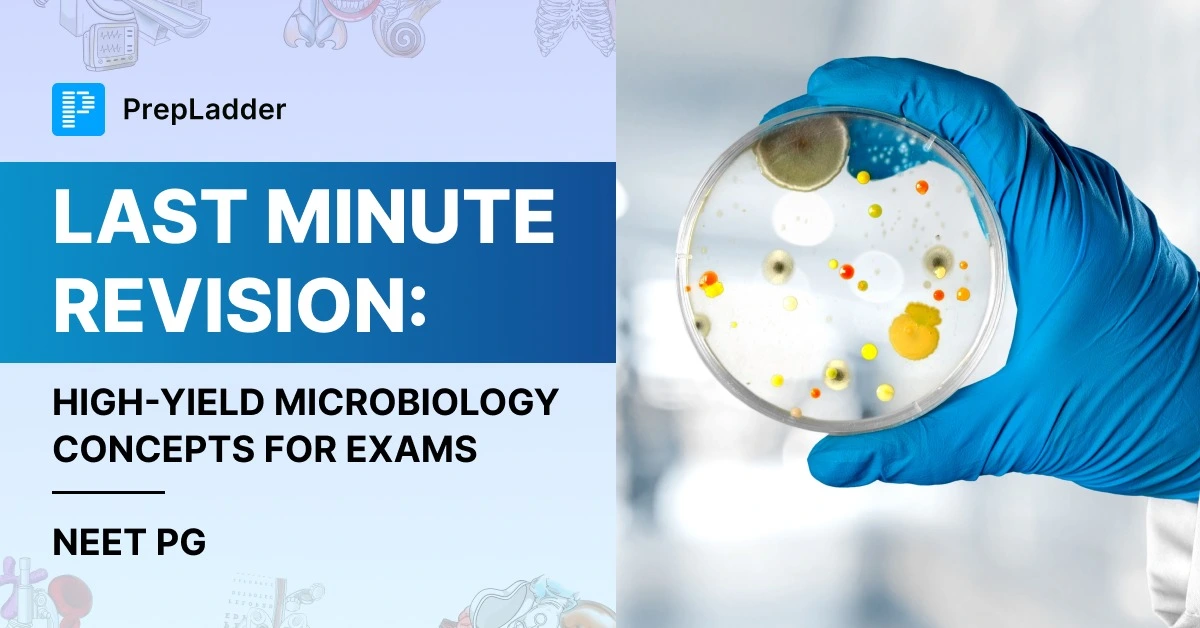
img
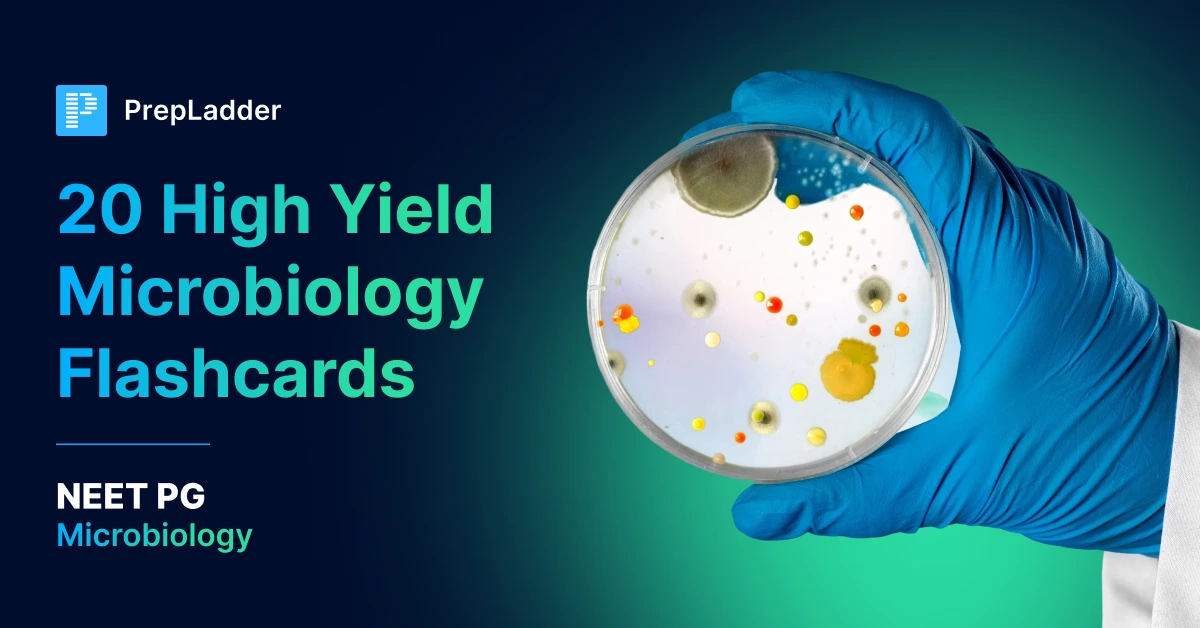
img

Microbiology for NEET PG
The microbiology section of the NEET PG exam tests the core knowledge of a student in medical microbiology, particularly the scientific basis of microbiology and infection. The section carries 80 marks, with 20 questions reserved in the entrance exam. Therefore, aspirants need to identify the best approach to prepare for microbiology. Once mastered, this can be a high-scoring subject.
Understanding Bacterial Structures: Cell Wall and MotilityThe bacterial cell wall is a primary structure used for classification.Gram-positive ba...

Q1. An 8-year-old boy presents with a 5-day history of severe sore throat, high fever, hoarseness of voice, and swollen neck. Physical examinatio...
Flashcard 1Differential Stains1. Gram stain (+/-)Mnemonic: Come In And StainCrystal Violet (primary stain)Iodine (mordant)Alcohol/ Acetone (decol...
How Does PrepLadder Make Microbiology Learning Easy for Students?
Students can benefit from PrepLadder’s clear and concise microbiology notes that cover the entire exam syllabus. High-quality images and graphs are embedded in the notes to make them more comprehensible and simplify learning. Plus, the NEET PG notes feature structured information and information boxes that aid quick recap of all topics. Besides notes, students can also learn from our engaging video lectures, treasures, & custom modules. We offer a vast QBank with clinically-oriented questions as per the latest exam pattern.
Meet our Microbiology Faculty
Dr. Preeti Sharma is our Microbiology faculty, and she has taught Microbiology to numerous batches of students both nationally and internationally. She has over 5 years of experience teaching students preparing for NEET PG, INICET, FMGE, USMLE, NURSING and DENTAL entrance exams. With her expertise in the subject, she will transform your Microbiology preparation like never before.

You are running out of time. Let me tell you a story.A 26-year-old MBBS graduate, three months after internship sits in front of 19 subjects and 200 u

Imagine a 28-year MBBS graduate who is taking the INI-CET exam. She has studied hard. She has read Harrisons twice, she has done 8,000 multiple-choice

Ranking Seats, NEET Cut-Off, Fees & AdmissionMedicine in the Mountains: Your Complete GuideI know a girl from Mandi who's 17 years old and wants to be
Avail 24-Hr Free Trial